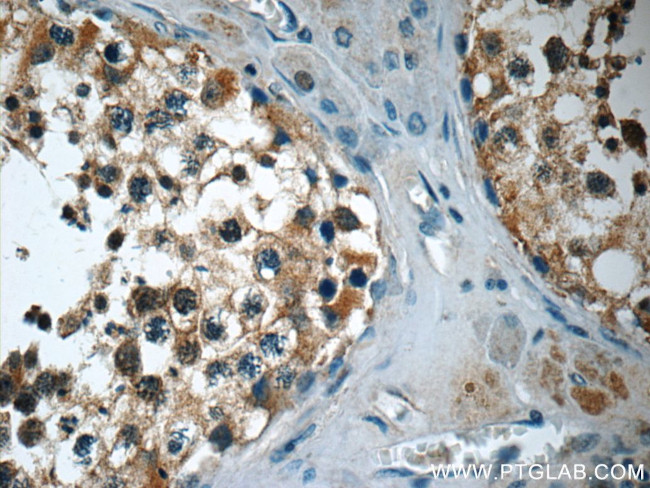
TEKT3 Antibody in Immunohistochemistry (Paraffin) (IHC (P))

Search
Proteintech
TEKT3 Polyclonal Antibody
{{$productOrderCtrl.translations['antibody.pdp.commerceCard.promotion.promotions']}}
{{$productOrderCtrl.translations['antibody.pdp.commerceCard.promotion.viewpromo']}}
{{$productOrderCtrl.translations['antibody.pdp.commerceCard.promotion.promocode']}}: {{promo.promoCode}} {{promo.promoTitle}} {{promo.promoDescription}}. {{$productOrderCtrl.translations['antibody.pdp.commerceCard.promotion.learnmore']}}
产品信息
12959-1-AP
种属反应
宿主/亚型
分类
类型
抗原
偶联物
形式
浓度
规格
纯化类型
保存液
内含物
保存条件
运输条件
产品详细信息
Immunogen sequence: MERVGCTLT TTYAHPRPTP TNFLPAISTM ASSYRDRFPH SNLTHSLSLP WRPSTYYKVA SNSPSVAPYC TRSQRVSENT MLPFVSNRTT FFTRYTPDDW YRSNLTNYQE SNTSRHNSEK LRVDTSRLIQ DKYQQTRKTQ ADTTQNLGER VNDIGFWKSE IIHELDEMIG ETNALTDVKK RLERALMETE APLQVARECL FHREKRMGID LVHDEVEAQL LTEVDTILCC QERMKLHLDK AIAQLAANRA SQHELEKDLS DKQTAYRIND KCHHLRNTSD GVGYFRGVER VDATVSVPES W (1-300 aa encoded by BC031688)
靶标信息
This gene product belongs to the tektin family of proteins. Tektins comprise a family of filament-forming proteins that are coassembled with tubulins to form ciliary and flagellar microtubules. The exact function of this gene is not known. Structural component of ciliary and flagellar microtubules. Forms filamentous polymers in the walls of ciliary and flagellar microtubules. Required for progressive sperm mobility.
仅用于科研。不用于诊断过程。未经明确授权不得转售。
篇参考文献 (0)
生物信息学
蛋白别名: Tektin-3; testicular microtubules-related protein; unnamed protein product
基因别名: 4933407G07Rik; SPGF81; TEKT3
UniProt ID: (Human) Q9BXF9, (Mouse) Q6X6Z7, (Rat) Q4V8G8
Entrez Gene ID: (Human) 64518, (Mouse) 71062, (Rat) 287392